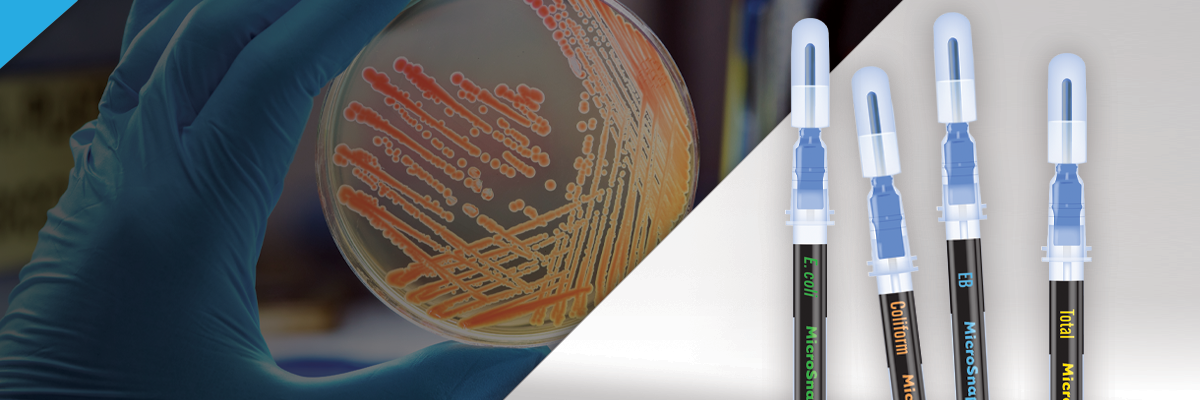

Hygiena™ ofrece soluciones rápidas de detección, monitoreo e identificación microbiana para una amplia gama de industrias, que incluyen alimentos y bebidas, atención médica, hospitalidad, productos farmacéuticos y cuidado personal. Utilizando tecnologías avanzadas y diseños patentados, Hygiena™ ofrece sistemas de monitoreo ATP líderes en la industria, detección de patógenos transmitidos por alimentos basada en PCR, sistemas de caracterización molecular de huellas dactilares de ADN, pruebas de alérgenos, dispositivos de recolección ambiental y más. Hygiena™ se compromete a proporcionar a los clientes tecnologías innovadoras de alta calidad que sean fáciles de usar y confiables, respaldadas por un excelente servicio y soporte al cliente. Con sede en Camarillo, California, oficinas en Wilmington, Delaware, el Reino Unido y China, y más de 80 distribuidores en más de 100 países en todo el mundo, los productos Hygiena™ se extienden por todo el mundo.
ARTIKA INDUSTRIAL representante de los productos y soluciones de HYGIENA en Chile